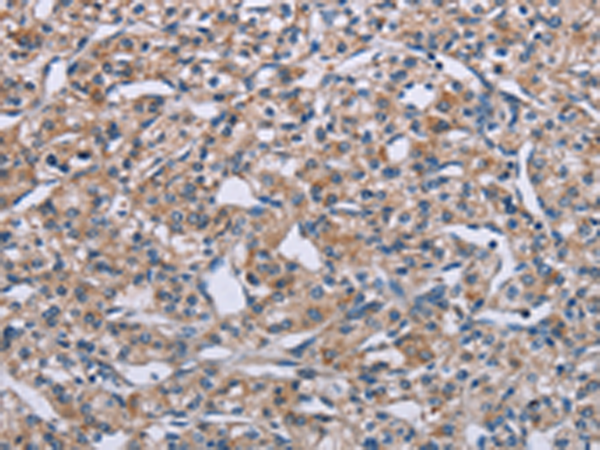
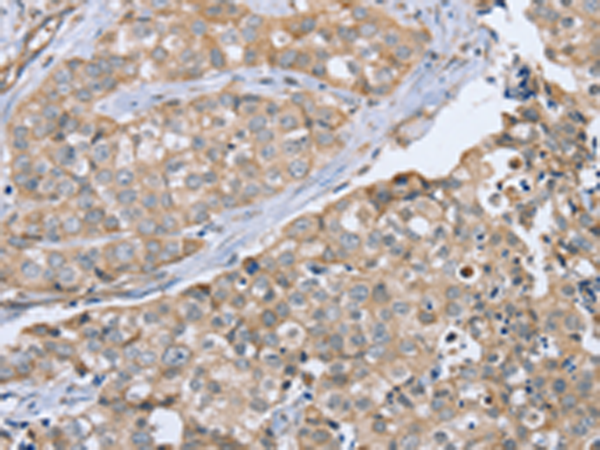

-
分类: 科研抗体货号: P12064别名: SEP; PLXN5; PLEXIN-B1应用: IHC反应种属: Human, Mouse
-
分类: 科研抗体货号: P12063别名: PLEXA4; PLXNA4A; PLXNA4B; FAYV2820; PRO34003应用: IHC反应种属: Human, Mouse
-
分类: 科研抗体货号: P12083别名: CT126; PTPN20A; PTPN20B; bA42B19.1; bA142I17.1应用: WB,IHC反应种属: Human
-
分类: 科研抗体货号: P12062别名: 6.3; PLXN3; PLXN4; XAP-6; HSSEXGENE应用: IHC反应种属: Human, Mouse, Rat
-
分类: 科研抗体货号: P12103别名: C10orf59; RENALASE应用: WB,IHC反应种属: Human, Mouse, Rat
-
分类: 科研抗体货号: P12080别名: PSD93; PSD-93; PPP1R58; chapsyn-110应用: IHC反应种属: Human
-
分类: 科研抗体货号: P12061别名: OCT; PLXN2应用: IHC反应种属: Human, Mouse
-
分类: 科研抗体货号: P12102别名: NOS; INOS; NOS2A; HEP-NOS应用: IHC反应种属: Human
-
分类: 科研抗体货号: P12079别名: B2-1; SEC7; PSCD1; D17S811E; CYTOHESIN-1应用: WB,IHC反应种属: Human, Mouse, Rat
-
分类: 科研抗体货号: P12060别名: NOV; NOVP; PLXN1; PLEXIN-A1应用: IHC反应种属: Human, Mouse

鄂公网安备42018502007531号
鄂公网安备42018502007531号

